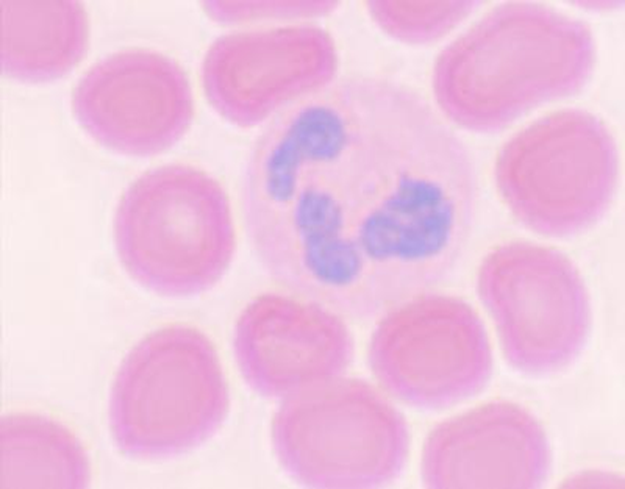
Histología animal

Preparaciones Microscópicas
Colecciones

Histología animal

Minerales

Zoología

Inicio » Preparaciones microscópicas
Inicio » Preparaciones microscópicas

Galiza Analítica S.L. ha sido beneficiaria del Fondo Europeo de Desarrollo Regional cuyo objetivo es mejorar el uso y la calidad de las tecnologías de la información y de las comunicaciones y el acceso a las mismas, y gracias al que ha podido mejorar su gestión empresarial, a través de la creación de Presencia web a través de página propia y Servicio de promoción online mediante sistema de pago (SEM). Esta acción ha tenido lugar durante la anualidad 2020. Para ello, ha contado con el apoyo del Programa TICCámaras de la Cámara de Comercio de Pontevedra, Vigo y Vilagarcía de Arousa


